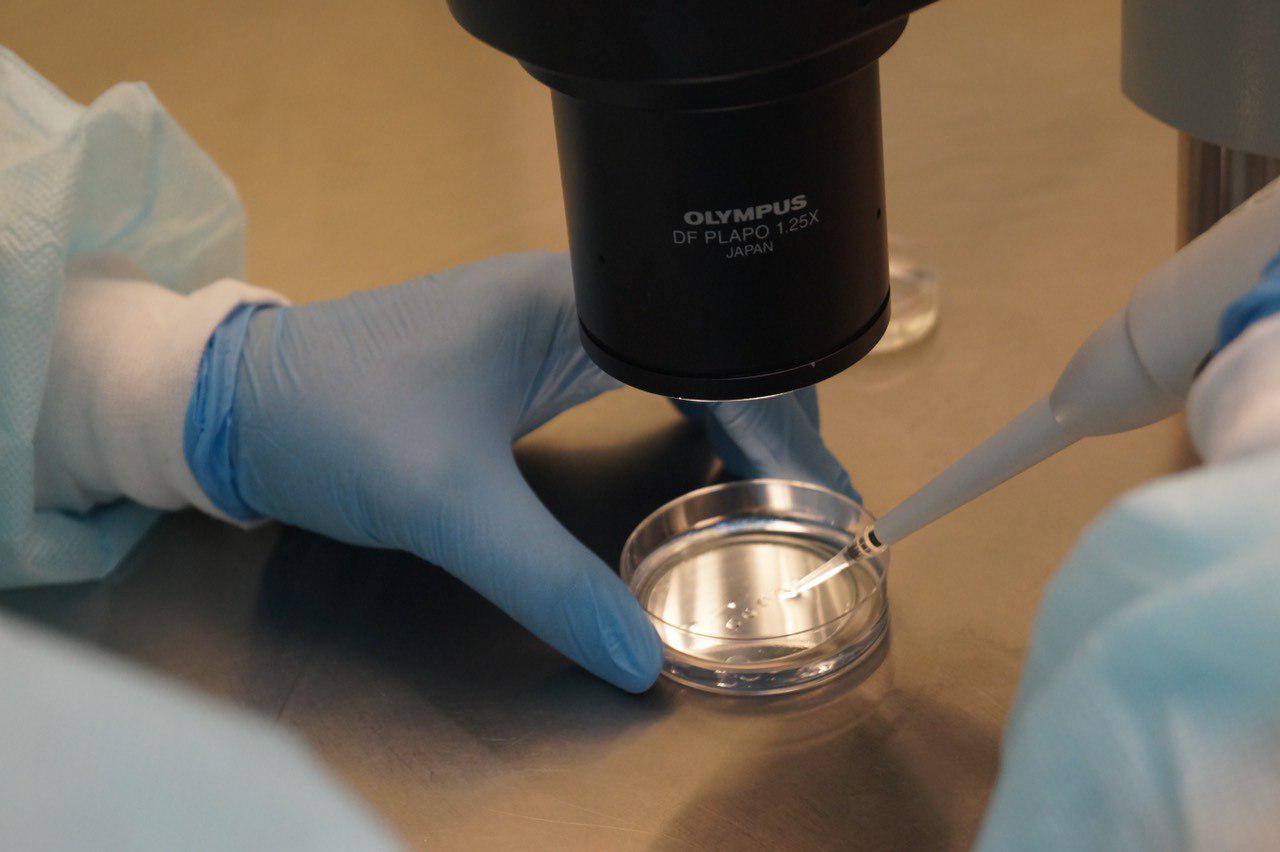

«Парамоновцы»: Для радости материнства нет преград
09:00, 18 апреля 2019
Главное предназначение человека - это продолжение рода, поэтому беременность, рождение ребенка - одни из самых желанных подарков, который люди ждут от жизни. Но, к сожалению, для некоторых людей забеременеть самостоятельно практически нет шансов. И тогда в дело вступают специалисты. Несколько следующих историй из практики сотрудников «Клиники доктора Парамонова» об этом.
Сегодня с нами беседовала заведующая Центром репродукции человека клиники Парамонова Екатерина Александровна Кулинская. Удивляет, насколько Екатерина Александровна любит свое дело и как тепло и заинтересованно рассказывает о каждом пациенте, о каждом примечательном случае, который остался в истории медицинского учреждения.
История 7.
Победа над бесплодием
История эта произошла в прошлом году. В клинику обратилась семейная пара - мужчине 34, женщина на год младше мужа. Супруги давно жили вместе, но детей у них не было, несмотря на многочисленные попытки.
По словам Кулинской, ситуация, с которой столкнулись врачи Центра репродукции, достаточно редкая. Обследование показало, что причина была в сильной половине.
«Там был чисто мужской фактор бесплодия. Причина - ретроградная эякуляция у мужа. То есть сперматозоид не попадает в эякулят, а происходит заброс спермы в мочевой пузырь. С этой патологией мужчина бесплоден. То есть получить своих детей естественным путем у него не получается», - пояснила Екатерина Кулинская.
Женщина в паре оказалась здоровой.
Тем не менее, медики посчитали, что помочь супругам можно. Единственный вариант - программа «ЭКО». Для того, чтобы пара могла в ней участвовать, нужно было каким-то образом получить сперматозоиды у мужчины.
«Они у него есть, и в яичках образуются, но только извлечь их сложно. Существует вариант, когда врачи консервативно пытаются получить сначала эти клетки из мочи. Мы пытались ощелачить мочу определенными препаратами. Центрифугировать, чтобы добыть эти сперматозоиды. Очень долго наши эмбриологи этим занимались. Надо отдать должное самому этому мужчине: он все выполнял, неоднократно приходил. Пробовали-пробовали, но проблема в том, что сперматозоиды в моче моментально погибают», - поясняет врач.
Попытки не увенчались успехом. Тогда специалистам Центра пришлось прибегнуть к оперативному способу. Была проведена биопсия яичка под наркозом. Это микрохирургическая операция, которая помогает получить сперматозоиды с последующим использованием. Операцию проводила уролог-андролог Елена Мещерякова.
«В результате были получены сперматозоиды. Правда, их было немного, единичные из них были морфологически нормальными. Провели оплодотворение супруги методом «ИКСИ» (оплодотворение в этом случае происходит при помощи микроманипуляции под микроскопом - ред), получили четыре эмбриона. Два ей перенесли в полость матки и два заморозили», - вспоминает Кулинская.
И вмешательство врачей принесло свои плоды. У женщины наконец-то наступила долгожданная беременность. Это произошло с первой же попытки.
Перед Новым 2019 годом у пары появился здоровый мальчик.
«Так они стали родителями. Еще у них хранятся два эмбриона - это на случай, если захотят второго ребенка. Эмбрионы могут храниться годами, никак от этого не страдая. Через два-три года они могут прийти к нам. Будет произведен перенос эмбрионов в полость матки, и у женщины может наступить вторая беременность. Вот такой был в нашей практике достаточно редкий случай с ретроградной эякуляцией, который закончился удачно», - улыбается заведующая Центром репродукции человека.
История 8.
«Непорочное материнство»
В «Клинике доктора Парамонова» болевшей с детства церебральным параличом женщине помогли обрести радость материнства.
Эта хрупкая маленькая пациентка надолго запомнится сотрудникам Центра репродукции человека. Несмотря на недуг, она проявила такие недюжинные волю и целеустремленность, которым позавидовали бы самые сильные духом мужчины.
«Пришла она к нам лет пять назад. Взрослая уже, года 32 ей было. Помню, заходит, невысокая, с такой своеобразной походочкой и говорит: «Я хочу ребенка. Но у меня мужчин никогда не было», - говорит Кулинская.
Доктора стали думать, чем могут ей помочь.
«Есть у нас донорские услуги - имеется замороженная донорская мужская сперма. Женщине делается инсеменация (введение в матку женщины спермы мужчины, полученной заблаговременно вне полового акта - ред.).
Если женщина абсолютно здорова, не бесплодна, это можно сделать. То есть в период овуляции размораживается образец спермы и вводится специальными катетерами в полость матки - моделируется естественный контакт. Но она девственница. Поэтому сначала первый этап был - нужно это препятствие устранить», - передает подробности заведующая Центра.
Пациентке провели хирургическую дефлорацию. А после она посетила несколько сеансов инсеменации - ей провели в общей сложности 4 процедуры.
«Это было очень мучительно для нее, потому что она элементарно не может улечься на гинекологическое кресло из-за дикого спазма ножек. Очень болезненно вводить какие-то инструменты, потому что у пациентки был сильный спазм мускулатуры. Она испытывала дикие боли - человек просто как комочек сжимался. Но настолько она хотела ребенка, что все это терпела», - поражается Елена Кулинская.
Но, несмотря на эти попытки, беременность все же не наступила. Решили делать ЭКО.
Однако попытки снова оказались напрасными: когда женщине делали ЭКО, во время наркоза у нее остановилось дыхание. Медики провели необходимые реанимационные действия, женщина пришла в себя. Через некоторое время ей пересадили эмбрион (манипуляция снова происходила под наркозом). Но беременность не наступила.
«Тогда она пошла на повторную программу ЭКО. Мы со своей стороны помогали, чем могли. Виктор Александрович Парамонов лично делал ей скидки бесконечные, рассрочки и т.д. В общем, пришла она на повторную программу, и все закончилось хорошо. Переносим эмбрион, и она беременеет. Вот что называется в чистом виде «непорочное зачатие». Причем ходит замечательно всю эту беременность. То есть у нее ни разу не было никаких угроз прерывания, как у обычных женщин. Никаких токсикозов», - радуется доктор.
Женщина выносила плод и родила ребенка, перенеся кесарево сечение.
«У нее появилась замечательная девочка, потрясающей красоты, с выразительными большими глазами. Потом она фотографии ее присылала. Девочка абсолютно здоровая, никаких проблем не было. Вот такая у нас была непорочная мама», - заключила Кулинская.
Продолжение следует...
На правах рекламы.
Имеются противопоказания,
необходима консультация специалиста.
- 1 Марата Алимбекова повысили до первого замминистра саратовского минсельхоза
- 2 В Саратове пять «кредитных специалистов» ждут суда за обман более 80 клиентов
- 3 В Саратове 25 бойцов СВО победили в предварительном голосовании «Единой России»
- 4 На бульваре по Астраханской убрали опоры освещения в рамках благоустройства
- 5 Правительство РФ выделит средства Саратовской области на общественный транспорт
- 1 В саратовских автобусах вводят сниженный пересадочный тариф
- 2 Масштабное отключение холодной воды в Саратове начнется предстоящей ночью
- 3 В Саратове сотрудники ФСБ задержали трех руководителей федерального ведомства
- 4 Пасквиль «Взгляда-инфо» Курихина подхватили «натовские» СМИ и сайты-помойки
- 5 Под мостом Саратов-Энгельс частично разрушился спуск к городскому пляжу







